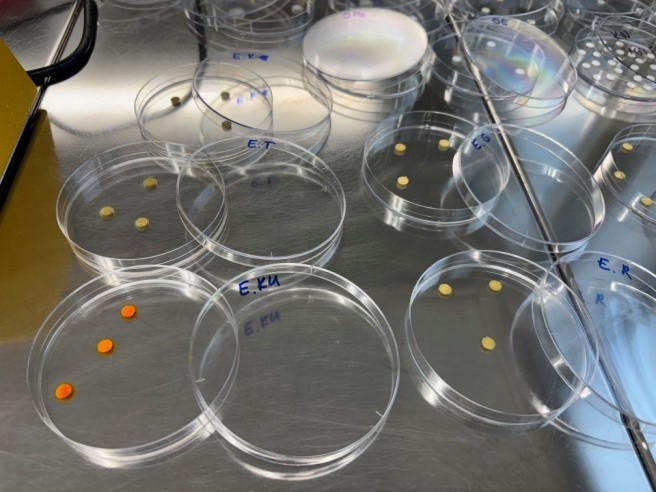
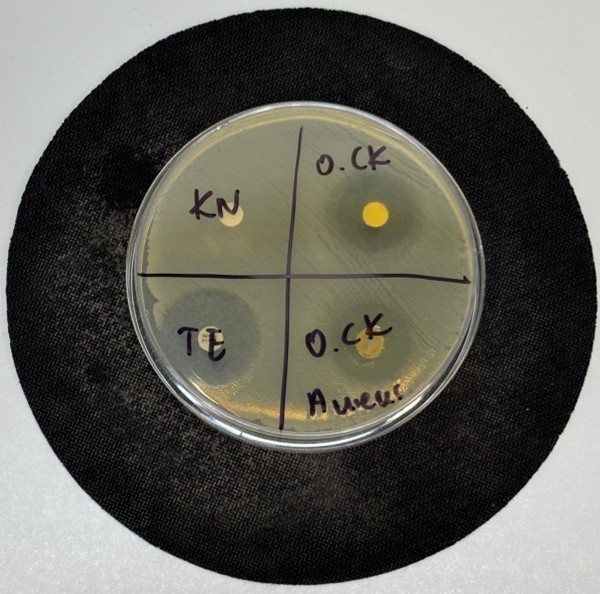
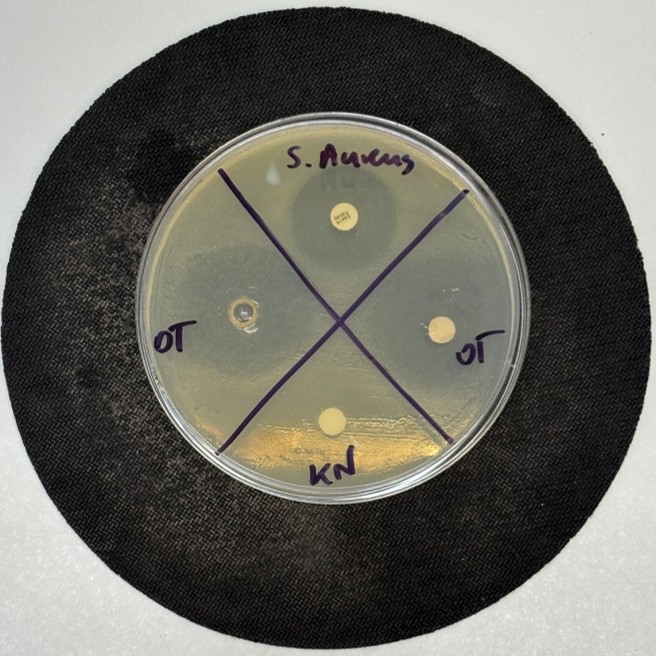
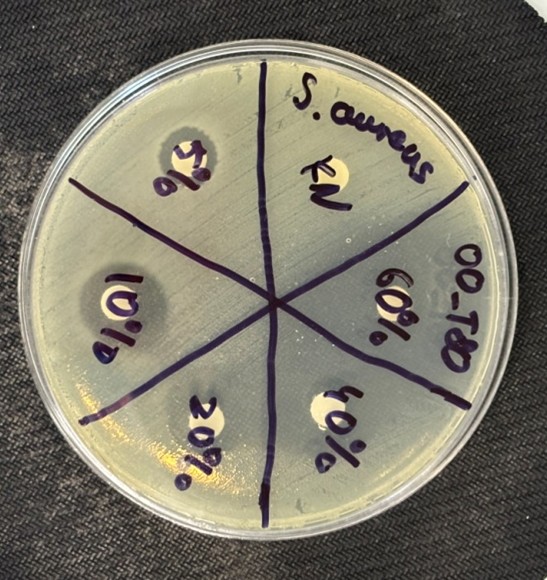
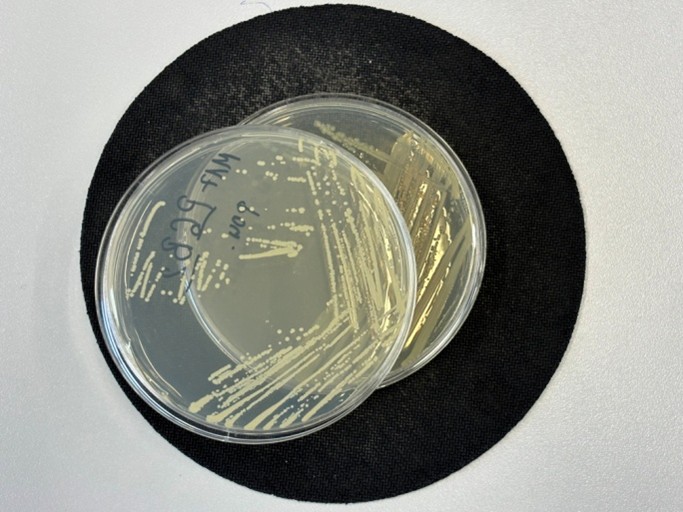
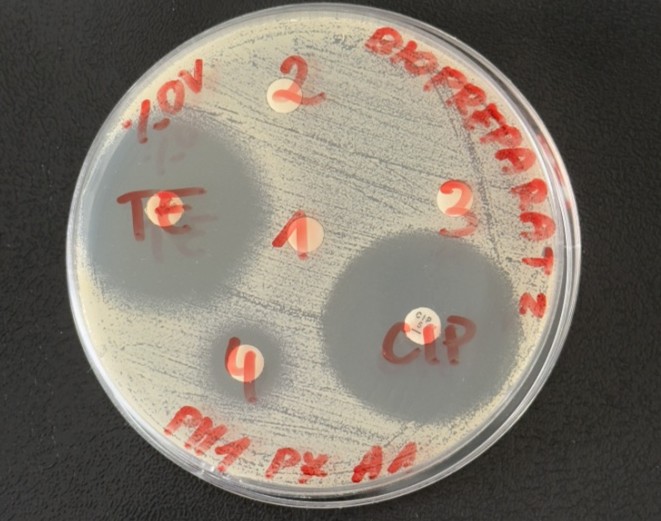

Projekt finansowany ze środków budżetu państwa, przyznanych przez Ministra Nauki i Szkolnictwa Wyższego w ramach Programu „Studenckie koła naukowe tworzą innowacje
(nr SKN/SN/630602/2025).
Okres realizacji: 10.04.2025 – 10.04.2026
Budżet projektu: 62 445 zł
Koordynatorzy naukowi: dr hab. Ilona Sadok, dr hab. Rafał Łopucki, prof. KUL
Przedmiot projektu:
Podczas realizacji przez Koło Naukowe Biotechnologii KUL wcześniejszego projektu z programu „Studenckie Koła Naukowe Tworzą Innowacje” (nr. SKN/SP/570395/2023) potwierdzono obecność potencjalnie chorobotwórczych bakterii, w tym lekoopornych szczepów, na placach zabaw w Lublinie. Wykazano tym samym, że przestrzeń publiczna, taka jak place zabaw, może stanowić istotne rezerwuary lekoopornych mikroorganizmów, narażając dzieci i osoby korzystające z tych miejsc na infekcje trudne do wyleczenia.
Przedmiotem obecnego projektu jest opracowanie biopreparatu o właściwościach bakteriobójczych dedykowanego do dezynfekcji elementów wyposażenia placów zabaw oraz potwierdzenie jego działania bakteriobójczego w stosunku do potencjalnie patogennych szczepów bakterii wykrywanych na terenie placów zabaw (tj. Escherichia coli, Staphylococcus aureus), w tym szczepów antybiotykoopornych. Skuteczność biopreparatu będzie weryfikowana w warunkach laboratoryjnych i plenarnych. W projekcie, planuje się wykorzystać komercyjnie dostępne surowce zielarskie i zaproponować prostą procedurę jego przygotowania możliwą do wykonania w warunkach domowych, tak aby biopreparat mógł być przygotowywany samodzielnie przez rodziców lub opiekunów dzieci.

Cele projektu:
- Podjęcie działań mających na celu ograniczenie rozpowszechniania się lekoopornych szczepów bakterii w bezpośrednim otoczeniu człowieka.
- Informowanie, edukowanie i uświadamianie społeczeństwa odnośnie zagrożeń wynikających z globalnego rozpowszechniania się zjawiska lekooporności mikroorganizmów.
- Budowanie wspólnej odpowiedzialności obywatelskiej w zakresie ograniczenia zjawiska lekooporności mikroorganizmów.
- Podniesienie świadomości społecznej, świadomości rodziców i przedsiębiorców na temat bezpieczeństwa mikrobiologicznego obiektów przeznaczanych dla najmłodszych.
- Promowanie stosowania naturalnych substancji o działaniu przeciwbakteryjnym do dezynfekcji powierzchni, z którymi mają kontakt dzieci.
- Zwiększenie bezpieczeństwa mikrobiologicznego na placach zabaw na terenach miejskich.
- Promowanie otwartego dostępu do wyników badań naukowych przez udostępnianie rezultatow projektu społeczeństwu.
- Pobudzanie pasji naukowych wśród studentów.
- Kształtowanie umiejętności wystąpień publicznych (prezentowanie wyników badań, przezwyciężanie tremy, prowadzenie dyskusji).
- Nabywanie umiejętności pracy w zespole przez członków Koła Naukowego.
- Umożliwienie prowadzenia badań przez członków Koła Naukowego wykraczających poza standardowy zakres programu studiów.
- Promowanie modelu nauczania opartego na Service-Learning polegającego na praktycznym wykorzystaniu wiedzy nabytej podczas studiów do rozwiązywania problemów ważnych dla społeczeństwa.

PRZEBIEG REALIZACJI PROJEKTU
Etap 1. Przegląd literatury i dobór surowców roślinnych
Pierwszy etap realizacji projektu obejmował systematyczny przegląd literatury naukowej, którego celem było wytypowanie surowców roślinnych o najbardziej obiecującym potencjale przeciwdrobnoustrojowym wobec bakterii Escherichia coli oraz Staphylococcus aureus - drobnoustrojów istotnych z punktu widzenia bezpieczeństwa mikrobiologicznego placów zabaw i powierzchni użytkowanych przez dzieci. Działania te były bezpośrednio powiązane z głównym celem projektu, jakim było opracowanie bezpiecznego, naturalnego biopreparatu o działaniu antybakteryjnym, możliwego do zastosowania w przestrzeniach przeznaczonych dla dzieci.
Na podstawie dostępnych publikacji naukowych, przeglądów systematycznych oraz danych dotyczących aktywności biologicznej ekstraktów/olejków roślinnych sporządzono wstępną listę potencjalnych surowców, uwzględniając ich wybrane części (np. liście, kwiaty, korzenie). Następnie dokonano krytycznej selekcji zaproponowanych surowców. Z dalszych analiz wykluczono te rośliny, dla których dostępne dane wskazywały na ograniczoną skuteczność przeciwdrobnoustrojową wobec co najmniej jednego z analizowanych patogenów lub których stosowanie mogło wiązać się z potencjalnym działaniem drażniącym, alergizującym bądź toksycznym, szczególnie w kontekście ekspozycji dzieci.
Istotnym kryterium doboru surowców była również ich dostępność i bezpieczeństwo użytkowania. Preferowano surowce roślinne (oraz ich części), które są dopuszczone do obrotu, powszechnie dostępne w aptekach lub sklepach zielarskich oraz znane typowym użytkownikom. Takie podejście było zgodne z założeniami projektu, zakładającymi możliwość praktycznego wdrożenia opracowanego biopreparatu oraz jego potencjalnego zastosowania poza warunkami laboratoryjnymi.
Efektem realizacji Etapu 1 było wytypowanie ograniczonej grupy surowców roślinnych, spełniających jednocześnie kryteria skuteczności przeciwdrobnoustrojowej, bezpieczeństwa stosowania oraz dostępności, które zostały zakwalifikowane do dalszych etapów badań eksperymentalnych.
Etap 2. Zakup naturalnych olejków eterycznych oraz przygotowanie ekstraktów roślinnych
W kolejnym etapie realizacji projektu przystąpiliśmy do pozyskania naturalnych olejków oraz przygotowania własnych ekstraktów roślinnych. Działania te stanowiły bezpośrednią kontynuację etapu analitycznego, w którym na podstawie przeglądu literatury naukowej wytypowano surowce o największym potencjale przeciwdrobnoustrojowym wobec Escherichia coli oraz Staphylococcus aureus.
W tym celu zakupiono komercyjnie dostępne, naturalne olejki eteryczne, charakteryzujące się udokumentowaną aktywnością biologiczną oraz szerokim zastosowaniem w produktach o charakterze higienicznym i biobójczym. Do badań zakwalifikowano olejki: oregano, tymianku, rozmarynu, cytryny, bergamotki FCF, goździków, cynamonu (kora), drzewa herbacianego, kolendry, szałwii muszkatołowej, mięty pieprzowej, melisy, eukaliptusa, majeranku, wanilii oraz lawendy. Dobór olejków uwzględniał ich dostępność, skuteczność przeciwdrobnoustrojową, jak i profil bezpieczeństwa istotny z punktu widzenia planowanego zastosowania preparatu w przestrzeniach przeznaczonych dla dzieci.
Równolegle z zakupem olejków eterycznych przeprowadzono laboratoryjne przygotowanie ekstraktów roślinnych z wyselekcjonowanych surowców w postaci suszu. Do ekstrakcji wykorzystano m.in.: kozieradkę, kurkumę, oregano, rozmaryn, tymianek, kolendrę oraz krwawnik. Proces ekstrakcji realizowano w warunkach laboratoryjnych z zastosowaniem ekstrakcji ultradźwiękowej z użyciem metanolu jako rozpuszczalnika, co pozwoliło na efektywne uwolnienie związków bioaktywnych obecnych w materiale roślinnym.
Każdy surowiec poddawano wieloetapowej ekstrakcji, obejmującej kilkukrotne zalewanie świeżą porcją rozpuszczalnika oraz wspomaganie procesu za pomocą ultradźwięków w temperaturze pokojowej. Uzyskane ekstrakty oddzielano od materiału roślinnego metodą sączenia próżniowego z wykorzystaniem lejka Büchnera, a następnie łączono w celu uzyskania jednorodnych próbek. Kolejnym etapem było zagęszczanie ekstraktów, prowadzone dwuetapowo: początkowo poprzez odparowanie rozpuszczalnika pod dygestorium, a następnie z wykorzystaniem koncentratora próżniowego, co umożliwiło skuteczne i kontrolowane usunięcie metanolu.
Proces odparowywania prowadzono aż do uzyskania suchej masy ekstraktu, co weryfikowano na podstawie stabilizacji masy próbek. Otrzymane suche ekstrakty charakteryzowały się różną wydajnością w zależności od rodzaju surowca, co odzwierciedla zróżnicowaną zawartość związków ekstrahowalnych. Uzyskane ilości suchego ekstraktu mieściły się w zakresie od kilkudziesięciu do ponad stu gramów, w zależności od rośliny, co zapewniło wystarczającą ilość materiału do dalszych badań biologicznych.
Gotowe ekstrakty zostały odpowiednio opisane i zdeponowane w warunkach chłodniczych, zgodnie z zasadami dobrej praktyki laboratoryjnej. Zarówno olejki eteryczne, jak i własnoręcznie przygotowane ekstrakty roślinne stanowią kluczowy materiał do kolejnych etapów projektu, obejmujących ocenę aktywności przeciwdrobnoustrojowej oraz opracowanie prototypowego biopreparatu przeznaczonego do bezpiecznego stosowania na placach zabaw.
Etap 3. Weryfikacja aktywności przeciwdrobnoustrojowej naturalnych komponentów biopreparatu
W kolejnym etapie realizacji projektu, przeprowadziliśmy badania mikrobiologiczne mające na celu laboratoryjną ocenę aktywności przeciwdrobnoustrojowej indywidualnych składników planowanego biopreparatu. Badania te stanowiły kluczowy etap weryfikacyjny, umożliwiający ocenę skuteczności poszczególnych naturalnych komponentów przed ich dalszym łączeniem i optymalizacją składu końcowego preparatu.
Analizie poddano 100% naturalne olejki eteryczne oraz ekstrakty roślinne rozpuszczone w odpowiednim rozpuszczalniku (woda/etanol), przygotowane w poprzednim etapie projektu. Celem prowadzonych badań było porównanie zdolności hamowania wzrostu drobnoustrojów przez poszczególne olejki i ekstrakty oraz identyfikacja tych frakcji, które wykazują najwyższą aktywność wobec bakterii istotnych z punktu widzenia bezpieczeństwa sanitarnego powierzchni użytkowych, w tym placów zabaw.
Badania mikrobiologiczne prowadziliśmy z wykorzystaniem szczepów referencyjnych bakterii powszechnie stosowanych w analizach aktywności przeciwdrobnoustrojowej, tj. Escherichia coli ATCC 25922 (Microbiologics) oraz Staphylococcus aureus ATCC 25923 (Microbiologics). Zastosowanie szczepów referencyjnych o znanej wrażliwości na substancje przeciwdrobnoustrojowe pozwoliło na uzyskanie wiarygodnych i porównywalnych wyników.
Analizy mikrobiologiczne prowadzono na podłożu Mueller-Hinton (MH), z wykorzystaniem zawiesin bakteryjnych o gęstości 0,5 w skali McFarlanda. Aktywność przeciwdrobnoustrojową ocenialiśmy metodami dyfuzyjnymi: krążkową oraz studzienkową (dołkową). Zastosowanie dwóch metod badawczych umożliwiło eliminację potencjalnych błędów interpretacyjnych wynikających z ograniczonej dyfuzji niektórych olejków eterycznych w agarze. W metodzie krążkowej na krążki bibułowe nanoszono po 20 µL 100% olejku eterycznego lub ekstraktu roślinnego lub kontroli negatywnej, którą stanowił 10% roztwór etanolu w wodzie. W metodzie studzienkowej do przygotowanych dołków aplikowaliśmy 20 µL kontroli negatywnej oraz 20 µL badanych ekstraktów. Na każdej płytce umieszczano również krążek z antybiotykiem referencyjnym - tetracykliną (TE 30), stanowiący kontrolę pozytywną badania. Po aplikacji badanych substancji płytki inkubowaliśmy w temperaturze 37°C przez 24 godziny. Po zakończonej inkubacji oceniano obecność oraz średnicę stref zahamowania wzrostu bakterii, co stanowiło podstawę do porównania skuteczności poszczególnych olejków eterycznych i ekstraktów roślinnych.
Przeprowadzone badania pozwoliły na laboratoryjną weryfikację aktywności mikrobiologicznej indywidualnych komponentów planowanego biopreparatu oraz na identyfikację substancji o najwyższym potencjale przeciwdrobnoustrojowym wobec E. coli i S. aureus. Uzyskane wyniki stanowią podstawę do dalszych prac nad doborem, łączeniem oraz optymalizacją składu biopreparatu, którego celem jest skuteczne i bezpieczne ograniczanie rozwoju drobnoustrojów na powierzchniach użytkowych w przestrzeniach przeznaczonych dla dzieci.
Etap 4. Selekcja aktywnych komponentów oraz wyznaczanie minimalnych stężeń hamujących (MIC)
W kolejnym etapie realizacji projektu przeprowadziliśmy porównawczą analizę skuteczności przeciwdrobnoustrojowej olejków eterycznych i ekstraktów roślinnych, której celem było zawężenie puli badanych materiałów roślinnych do tych wykazujących rzeczywistą aktywność biologiczną wobec bakterii referencyjnych Escherichia coli oraz Staphylococcus aureus. Etap ten miał kluczowe znaczenie dla racjonalnego doboru składników przeznaczonych do dalszych prac nad formulacją biopreparatu.
Na podstawie wcześniejszych badań zaobserwowaliśmy istotne różnice w aktywności przeciwdrobnoustrojowej pomiędzy olejkami eterycznymi a ekstraktami roślinnymi. Olejki eteryczne wykazywały wyraźnie silniejsze działanie hamujące wzrost bakterii, przy czym efektywność ich działania była zróżnicowana i zależna od pochodzenia roślinnego. W przypadku części badanych olejków oraz ekstraktów nie zaobserwowano istotnej aktywności przeciwdrobnoustrojowej wobec E. coli i S. aureus; związki te nie zostały uwzględnione jako „core” aktywny biopreparatu, jednak pozostają rozważane jako potencjalne dodatki formulacyjne, poprawiające m.in. zapach, wygląd, klarowność lub właściwości fizykochemiczne preparatu.
Dla materiałów roślinnych, dla których obserwowano powstawanie stref zahamowania wzrostu bakterii wokół krążków lub studzienek, przeprowadzono test minimalnego stężenia hamującego (MIC, Minimal Inhibitory Concentration). Celem tego etapu było ilościowe określenie najniższego stężenia substancji, przy którym zachowana jest aktywność przeciwdrobnoustrojowa.
Ze względu na hydrofobowy charakter olejków eterycznych, przed wykonaniem testów MIC zastosowano rozcieńczanie w wodno-etanolowym roztworze z dodatkiem Tween 20 oraz Tween 80, które zostały wytypowane jako naturalne solubilizatory do przygotowania biopreparatów ułatwiające jednorodne mieszanie olejków z fazą wodną.
Testy MIC prowadzono równolegle z wykorzystaniem metody krążkowo-dyfuzyjnej oraz studzienkowej, każdorazowo stosując odpowiednie kontrole negatywne oraz antybiotyk referencyjny - tetracyklinę (TE 30) - jako kontrolę pozytywną. Badania wykonywano na szczepach referencyjnych: Escherichia coli ATCC 25922 (Microbiologics) oraz Staphylococcus aureus ATCC 25923 (Microbiologics), co zapewniło porównywalność i wiarygodność uzyskanych wyników.
Realizacja tego etapu umożliwiła wyłonienie najbardziej efektywnych komponentów roślinnych oraz określenie ich aktywnych zakresów stężeń, stanowiąc podstawę do dalszych prac nad optymalizacją składu i formulacją finalnego biopreparatu przeznaczonego do bezpiecznego stosowania na placach zabaw.
Etap 5. Reidentyfikacja szczepów środowiskowych i weryfikacja profilu antybiotykooporności
Dokonanaliśmy ponownej identyfikacji gatunkowej szczepów środowiskowych pochodzących z banku izolatów bakterii, który został utworzony w ramach wcześniejszego projektu „Antybiotykooporność bakterii: globalne wyzwanie - lokalne działanie” („Studenckie koła naukowe tworzą innowacje”, nr SKN/SP/570395/2023). Identyfikacja prowadzona była za pomocą techniki MALDI-TOF MS, zgodnie z protokołami opracowanymi w ramach poprzedniego projektu.
Po potwierdzeniu tożsamości gatunkowej wszystkie szczepy poddano ponownej ocenie wrażliwości na wybrane antybiotyki, wykorzystując klasyczną metodę dyfuzyjno-krążkową z krążkami nasączonymi antybiotykami. Takie działania były niezbędne, ponieważ dokładna identyfikacja gatunkowa oraz wyznaczenie profilu antybiotykooporności szczepów środowiskowych są kluczowe przed testowaniem efektywności biopreparatu.
Etap ten stanowił kluczowy krok walidacyjny, który gwarantuje rzetelność i powtarzalność badań mikrobiologicznych nad biopreparatami, będących celem dalszych testów laboratoryjnych i terenowych.
Etap 6. Opracowanie i optymalizacja biopreparatów do dezynfekcji powierzchni na placach zabaw
W kolejnym etapie realizacji projektu skoncentrowaliśmy się na opracowaniu i laboratoryjnej optymalizacji preparatów na bazie wyselekcjonowanych substancji naturalnych, przeznaczonych do dezynfekcji powierzchni użytkowych. Celem było opracowanie skutecznych, bezpiecznych i stabilnych formulacji, które mogłyby znaleźć zastosowanie w przestrzeniach przeznaczonych dla dzieci.
Badania prowadzono na różnych kombinacjach składników, obejmujących minimum trzy wybrane materiały roślinne o potwierdzonej aktywności przeciwdrobnoustrojowej, wodę, etanol w różnych stężeniach oraz naturalne solubilizator (różne rodzaje i stężenia). Optymalizacja formulacji uwzględniała zarówno skuteczność mikrobiologiczną, jak i właściwości fizykochemiczne preparatu, takie jak stabilność i jednorodność zawiesiny.
Do oceny aktywności przeciwdrobnoustrojowej wykorzystano zarówno szczepy referencyjne: Escherichia coli (ATCC 25922, NCTC 13353 i 13476) oraz Staphylococcus aureus (ATCC 25923 i 700699) jak i szczepy środowiskowe pochodzące z banku bakterii wyizolowanych w ramach poprzedniego projektu „Antybiotykooporność bakterii: globalne wyzwanie - lokalne działanie” („Studenckie koła naukowe tworzą innowacje”, nr SKN/SP/570395/2023). Takie podejście pozwoliło na ocenę efektywności preparatów zarówno wobec szczepów laboratoryjnych, jak i realnych mikroorganizmów środowiskowych.
W ramach prowadzonych eksperymentów systematycznie ocenialiśmy wpływ rodzaju oraz stężenia solubilizatora na właściwości otrzymywanych preparatów. Zaobserwowaliśmy, że obecność solubilizatora w różny sposób oddziałuje na klarowność biopreparatu, w zależności od rodzaju oraz procentowego udziału materiałów roślinnych zastosowanych w formulacji. Jednocześnie wykazaliśmy, że w określonych warunkach jego obecność może prowadzić do ograniczenia aktywności przeciwdrobnoustrojowej. Analiza tych zależności umożliwiła opracowanie kilku oryginalnych formulacji, które wykazały skuteczną inhibicję wzrostu zarówno E. coli, jak i S. aureus.
W badaniach mikrobiologicznych stosowano kontrole pozytywne, tj. tetracyklinę (TE 30) i ciprofloxacin (CIP 5), co umożliwiło porównanie aktywności preparatów naturalnych z działaniem klasycznych środków antybakteryjnych. Wyniki tego etapu pozwoliły na wyłonienie najbardziej obiecujących kompozycji, które będą podstawą do dalszych badań nad bezpieczeństwem, stabilnością i możliwym zastosowaniem w środowisku placów zabaw.
EFEKTY PROJEKTU
Doniesienia konferencyjne
- Panasiuk, K. Ożga, I. Sadok, R. Łopucki, Biopreparat dla bezpiecznych placów zabaw- projekt Koła Naukowego Biotechnologii KUL, Konferencja “Od kodu życia do medycyny przyszłości”, 13.06.2025 r. Lublin (poster)
- Potyra, A. Niziołek, R. Łopucki, I. Sadok, Biobójcze właściwości Echinacea purpurea i Allium sativum oraz możliwości ich wykorzystania we wspieraniu zdrowia publicznego, Konferencja “Od kodu życia do medycyny przyszłości”, 13.06.2025 r. Lublin (poster)
- Ożga, N. Panaisuk, M. Potyra, R. Łopucki, I. Sadok, Plant-based biopreparation with bactericidal activity against Escherichia coli and Staphylococcus aureus strains isolated from urban playgrounds – Preliminary study, 4th International Conference on Microbiology & Infectious Diseases, 27-28.10.2025, Berlin, Germany (oral presentation based on an e-poster)
- M. Potyra, N. Panasiuk, K. Ożga, R. Łopucki, I. Sadok, Formulation optimization of an essential oil-based biopreparation, Ogólnopolska Konferencja Naukowa XI Forum Młodych Naukowców „Nauki przyrodnicze i medyczne”, 21.11.2025, Lublin, Polska (e-poster).
Artykuły naukowe
- R. Łopucki, M. Skowronek, A. Bilokinna,, G. Martinez-de-Tejada, I. Sadok, Awareness of microbiological safety in playgrounds amid rising antibiotic resistance, Environmental Microbiology Report 2025, 17(6), e70241, doi: 10.1111/1758-2229.70241
Nagrody i wyróżnienia
- NagrodaIII stopnia za najlepszy plakat naukowy pt. : „Formulation optimization of an essential oil-based biopreparation” zaprezentowany przez Monikę Potyrę podczas Ogólnopolskiej Konferencji Naukowej XII Forum Młodych Naukowców „Nauki przyrodnicze i medyczne” w dniu 21 listopada 2025 r.
DZIAŁANIA PROMUJĄCE WYNIKI PROJEKTU
Udział w konferencjach naukowych i seminariach
| 13 czerwca 2025 r. |
Udział w konferencji “Od kodu życia do medycyny przyszłości” Prezentacja 2 plakatów naukowych podejmujących tematykę projektu. Aktywne uczestnictwo 4 członkiń Koła.
|
| 24 października 2025 r. |
Udział w II Międzyuczelnianym Seminarium Kół Naukowych Seminarium miało miejsce w budynkach Wydziału Medycznego KUL i zrzeszało studentów z Koła Naukowego Biotechnologii KUL, Koła Naukowego Studentów Architektury Krajobrazu KUL oraz studentów i wykładowców z Holy Cross College, St. Mary’s College i University of Notre Dame (South Bend, Indiana, USA). Prezentacja projektu i jego założeń.
|
| 27-28 października 2025 r. |
Udział w 4th International Conference on Microbiology & Infectious Diseases Prezentacja plakatu naukowego omawiającego wyniki projektu. Aktywne uczestnictwo 1 członkini Koła.
|
| 21 listopada 2025 r. |
Udział w Ogólnopolskiej Konferencji Naukowej XII Forum Młodych Naukowców „Nauki przyrodnicze i medyczne” Prezentacja plakatu naukowego omawiającego wyniki projektu. Aktywne uczestnictwo 1 członkini Koła.
Plakat prezentowany podczas konferencji zdobył III nagrodę za najlepszy plakat naukowy zaprezentowany podczas "Forum Młodych Naukowców". Współautorzy: Natalia Panasiuk, Kinga Ożga oraz koordynatorzy naukowi projektu.
|
| 11 grudnia 2025 r. |
Udział w Dniu Organizacji Studenckich KUL i prezentacja działalności projektowej Koła. Wydarzeniu towarzyszyła świąteczna atmosfera połączona ze świętowaniem 107. urodzin KUL. Wydarzenie było okazją do zaprezentowania biopreparatów o działaniu antybakteryjnym, przygotowanych na bazie naturalnych olejków przygotowywanych w ramach projektu „Biopreparat dla bezpiecznych placów zabaw”. Na stoisku przedstawialiśmy dwie oryginalne kompozycje o potwierdzonej aktywności bakteriostatycznej wobec S. aureus i E. coli. |
| 16 grudnia 2025 r. |
Udział w wydarzeniu „IGNIS - Polska sięga gwiazd” - ogólnopolskiej trasy technologiczno-naukowej misji IGNIS z udziałem polskiego astronauty, dr Sławosza Uznańskiego-Wiśniewskiego.
Podczas rozmowy z dr Sławoszem Uznańskim-Wiśniewskim opowiadaliśmy o biopreparatach tworzonych w ramach grantu „Studenckie Koła Naukowe Tworzą Innowacje”. Na pamiątkę astronauta otrzymał od nas buteleczkę biopreparatu o potwierdzonej aktywności mikrobiologicznej i przyjemnym, korzennym zapachu. |
| 16 stycznia 2026 r. |
Noc Biologów 2026 – warsztaty laboratoryjne z przygotowania biopreparatów z naturalnych olejków
Warsztaty odbywały się pod hasłem: „Moc ziół w praktyce – naturalne preparaty antybakteryjne”. W trakcie warsztatów uczestnicy poznali receptury trzech biopreparatów na bazie naturalnych olejków eterycznych, których skuteczność przeciwko Escherichia coli oraz Staphylococcus aureus została potwierdzona badaniami. Co najważniejsze – każdy mógł samodzielnie przygotować własny preparat przeznaczony do dezynfekcji powierzchni.
Kierownik warsztatów: Kinga Ożga. Współprowadzący: Kuba Marzec, Martyna Niedźwiecka, Sylwia Marczewska, Natalia Panasiuk, Iryna Parashchak, Monika Potyra, Wojciech Borys |
Ostatnia aktualizacja: 01.02.2026, godz. 18:58 - Rafał Łopucki